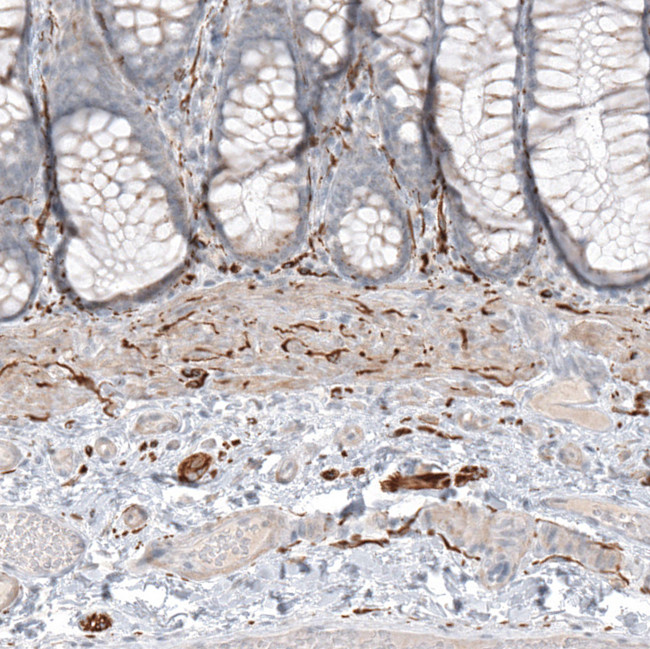
CD171 Antibody in Immunohistochemistry (Paraffin) (IHC (P))

Search
Invitrogen
CD171 Polyclonal Antibody
{{$productOrderCtrl.translations['antibody.pdp.commerceCard.promotion.promotions']}}
{{$productOrderCtrl.translations['antibody.pdp.commerceCard.promotion.viewpromo']}}
{{$productOrderCtrl.translations['antibody.pdp.commerceCard.promotion.promocode']}}: {{promo.promoCode}} {{promo.promoTitle}} {{promo.promoDescription}}. {{$productOrderCtrl.translations['antibody.pdp.commerceCard.promotion.learnmore']}}
产品信息
PA5-82219
种属反应
宿主/亚型
分类
类型
抗原
偶联物
形式
浓度
规格
纯化类型
保存液
内含物
保存条件
运输条件
RRID
产品详细信息
Immunogen sequence: ELRTHNLTDL SPHLRYRFQL QATTKEGPGE AIVREGGTMA LSGISDFGNI SATAGENYSV VSWVPKEGQC NFRFHILFKA LGEEKGGASL SPQYVSYNQS SYTQWDLQPD TDYEIHLFKE RMFRHQMAVK TNGTGRVRLP PAGFATE
Highest antigen sequence indentity to the following orthologs: Rat - 75%, Mouse - 75%.
靶标信息
L1CAM/CD171 is an axonal glycoprotein belonging to the immunoglobulin supergene family. The ectodomain, consisting of several immunoglobulin-like domains and fibronectin-like repeats (type III), is linked via a single transmembrane sequence to a conserved cytoplasmic domain. This cell adhesion molecule plays an important role in nervous system development, including neuronal migration and differentiation. Mutations in the gene cause three X-linked neurological syndromes known by the acronym CRASH (corpus callosum hypoplasia, retardation, aphasia, spastic paraplegia and hydrocephalus). Alternative splicing of a neuron-specific exon is thought to be functionally relevant.
仅用于科研。不用于诊断过程。未经明确授权不得转售。
篇参考文献 (0)
生物信息学
蛋白别名: antigen identified by monoclonal antibody R1; CD 171; CD171; CD171 molecule; IgG super gene family; N-CAM-L1; Neural cell adhesion molecule L1; sCD171; sL1 CAM; sL1CAM; soluble CD 171; soluble CD171; soluble L1 CAM; soluble L1CAM; unnamed protein product
基因别名: CAML1; CD171; HSAS; HSAS1; HYCX; L1CAM; MASA; MIC5; N-CAM-L1; N-CAML1; NCAM-L1; S10; SPG1
UniProt ID: (Human) P32004
Entrez Gene ID: (Human) 3897